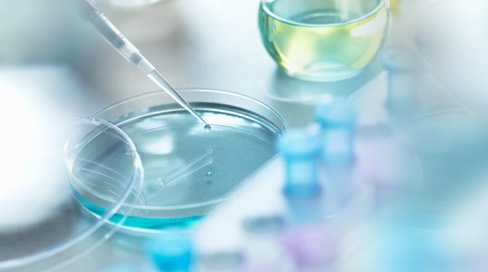
Petri dish with an eye dropper putting in some liquid.

Carle Health surgeon, CI MED research team develop system to pinpoint malignant lymph nodes
Research for Patients
At Carle Health, we believe the clinical trials of today will become the therapies of the future. For more than 40 years, we’ve advanced medicine by offering our patients cutting-edge treatment options and access to high-quality clinical trials. We encourage meaningful conversations as you consider if being a part of a clinical study is right for you.